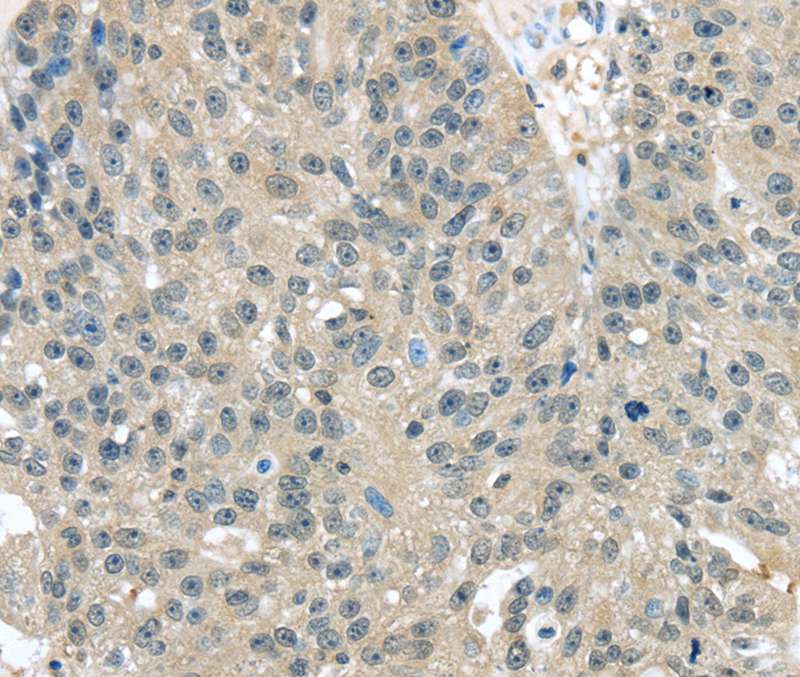
Anti-TXNDC17 Antibody

Immunohistochemical staining of human cerebellum shows strong cytoplasmic positivity in Purkinje cells.
Anti-TXNDC17 Antibody
HPA022931
ApplicationsWestern Blot, ImmunoHistoChemistry
Product group Antibodies
ReactivityHuman
TargetTXNDC17
Overview
- SupplierAtlas Antibodies
- Product NameAnti-TXNDC17 Antibody
- Delivery Days Customer4
- ApplicationsWestern Blot, ImmunoHistoChemistry
- CertificationResearch Use Only
- ClonalityPolyclonal
- ConjugateUnconjugated
- Gene ID84817
- Target nameTXNDC17
- Target descriptionthioredoxin domain containing 17
- Target synonymsTRP14, TXNL5, thioredoxin domain-containing protein 17, 14 kDa thioredoxin-related protein, protein 42-9-9, testicular tissue protein Li 214, thioredoxin (Trx)-related protein, 14 kDa, thioredoxin-like 5, thioredoxin-like protein 5
- HostRabbit
- IsotypeIgG
- Protein IDQ9BRA2
- Protein NameThioredoxin domain-containing protein 17
- Scientific DescriptionRecombinant Protein Epitope Signature Tag (PrEST) antigen sequence
- ReactivityHuman
- Storage Instruction-20°C,2°C to 8°C
- UNSPSC41116161